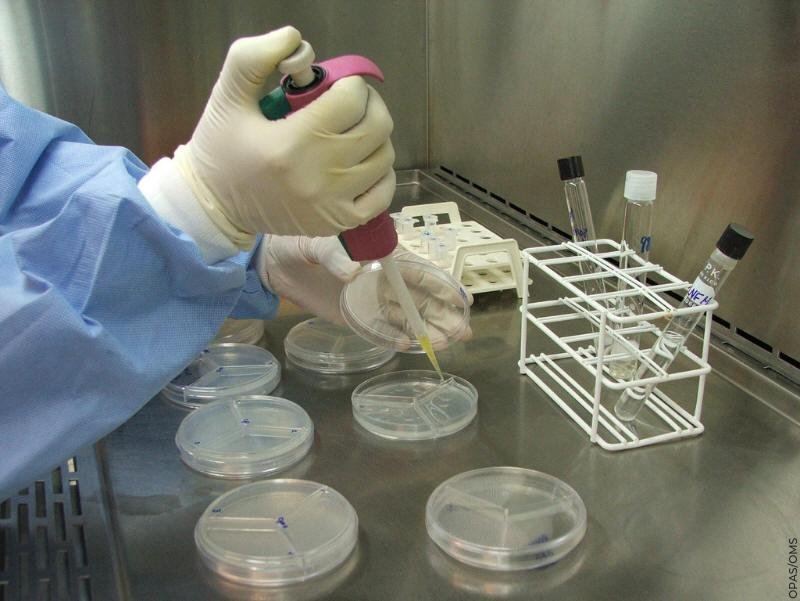

Brasil confirma primeiro caso de coronavírus e mais de 252 suspeitos *
Trata-se de um homem de 61 anos, residente de São Paulo e que, segundo a Agência Nacional de Vigilância Sanitária (ANVISA) esteve a trabalho na Itália, na região da Lombardia, por um período de 12 dias
O Ministério da Saúde por meio de coletiva de imprensa realizada na quarta-feira (26) confirmou o primeiro caso de coronavírus (COVID-19) no Brasil, e anunciou medidas de controle e prevenção. Trata-se de um homem de 61 anos, residente de São Paulo e que, segundo a Agência Nacional de Vigilância Sanitária (ANVISA) esteve a trabalho na Itália, na região da Lombardia, por um período de 12 dias.
O brasileiro, que não teve seu nome divulgado retornou de viagem em um voo com escala em Paris, na sexta-feira (21) e realizou uma reunião familiar com cerca de 30 pessoas no domingo (23). Após apresentar sintomas como febre, tosse dor de garganta e coriza, o paciente procurou o Hospital Albert Einstein, em São Paulo, na segunda-feira (24). Todos os familiares estão sob monitoramento da vigilância sanitária.
Segundo explica o Ministro da Saúde, Luiz Henrique Mandetta, os passageiros que estavam no avião com o paciente não ficarão em quarentena. Apenas devem ficar em observação aqueles passageiros com maior proximidade da poltrona do paciente. “São as duas fileiras à frente. O indivíduo (infectado) está sentado nessa fileira. Então pega-se as laterais dele, a da frente e a outra. Essas pessoas são contactadas pela Anvisa”, explicou o ministro. Ele acrescenta que algumas medidas já foram tomadas prevendo um cenário de emergência, e frisa que a população precisa ter calma. “Nós vamos nos preparar da melhor maneira. Mas é preciso ter calma. É uma gripe, vamos passar por ela e colocar todas as fichas na ciência”, disse.
Já o paciente deve ficar em isolamento em sua residência durante 14 dias e somente poderá ser levado ao hospital se o quadro piorar. “Não existe um remédio específico que trate o coronavírus. A recomendação do Ministério da Saúde é repouso e medicação de apoio, além de acompanhar a evolução diária da doença.”, declara Henrique Mandetta.
O Ministério da Saúde ainda afirma que o cenário atual é de contenção, quando procura-se evitar que o vírus se espalhe, caso aconteça, a situação vai entrar em fase de mitigação, ou seja, evitar casos graves e óbitos.
Casos suspeitos
Na quinta-feira (27) o Secretário Executivo do Ministério da Saúde, João Gabbardo, atualizou o número de casos suspeitos. Até o fechamento dessa edição do Correio da Semana, o número tinha evoluído de 20 para 132 suspeitos em 24 horas. Ele acrescenta que ainda há casos que estão sendo enviados ao governo federal pelas prefeituras, e que o total de suspeitos deve se aproximar de 300.
Dos 252 casos suspeitos, cinco são de pessoas do Ceará, quatro deles estão na capital do estado e um caso em Crateús. A secretária executiva da Vigilância e Regulação da Secretaria de Saúde do Estado do Ceará (SESA) Magda Almeida, ressalta que o acompanhamento dos casos suspeitos está sendo feito por meio da vigilância do Estado.
Como se prevenir do coronavírus
Sem tratamento específico, os cuidados com a higiene é o fator crucial para a prevenção da doença causada pelo novo coronavírus. O Ministério da Saúde recomenda lavar as mãos com frequência antes de consumir algum alimento e após tossir ou espirrar, não compartilhar objetos de uso pessoal, como talheres, copos, pratos ou garrafas, manter os ambientes bem ventilados, cobrir nariz e boca quando espirrar ou tossir, evitar contato próximo com as pessoas que apresentam sinais ou sintomas da doença, além de utilizar lenço descartável para higiene nasal.
Antecipação da campanha de vacinação contra a gripe
O ministério da Saúde antecipou a campanha de vacinação contra a gripe prevista para abril. Agora serão disponibilizadas 75 milhões de doses a partir do dia 23 de março em todo o país. O ministério afirma que, embora a vacina não projeta contra o coronavírus, ajudará a combater os demais vírus associados a outros tipos de gripes e diminuirá a sobrecarga do sistema de saúde. “Se não fizermos a vacina da gripe, teremos muito mais pessoas com síndrome gripal. Além das pessoas que estarão com coronavírus, também teremos pessoas contaminadas com outro tipo de influenza. Facilita muito também para o profissional fazer o diagnóstico”, afirmou João Gabbardo.









